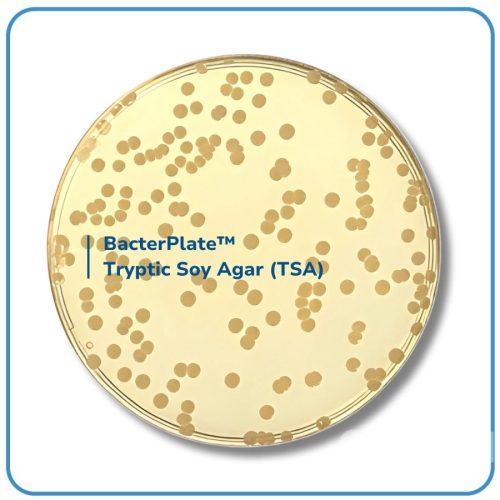

BacterPlate™ Tryptic Soy Agar (TSA)
Mã: 05026
Mã đặt hàng/sản phẩm: 4102013
Số lượng tối thiểu: 1
- BacterPlate™ Tryptic Soy Agar (TSA) là một môi trường dinh dưỡng phổ quát, phù hợp với nhiều ứng dụng khác nhau. Với giá trị dinh dưỡng cao, môi trường này có thể được sử dụng để nuôi cấy và phân lập cả vi khuẩn hiếu khí và kỵ khí, đồng thời hỗ trợ sự phát triển của các vi sinh vật khó tính nhất. Khi được đổ thành đĩa hoặc dải, TSA rất hữu ích trong các thử nghiệm nhanh để kiểm tra sự nhiễm bẩn trên bề mặt. Ngoài ra, dưới tên gọi TSA (Tryptic Soy Agar), công thức này tương ứng với môi trường tham chiếu được sử dụng để đánh giá tiêu chí năng suất và tính chọn lọc trong tiêu chuẩn ISO 11133.
- Thành phần trong 1L môi trường (tham khảo): Tryptone; Papaic digest of soybean meal; Sodium chloride; Agar. pH của môi trường hoàn chỉnh ở 25°C: 7,3 ± 0,2.
- Quy cách: 10 đĩa/ hộp hoặc theo yêu cầu của khách hàng.
- Bảo quản lưu trữ: 2 – 8°C.
- Vận chuyển: Nhiệt độ môi trường.
- Hạn sử dụng: 04 tháng kể từ ngày sản xuất.
Danh sách đặt hàng
BacterPlate™ Tryptic Soy Agar (TSA)
Mã: 4102013
Đơn vị: Đĩa
| Tên sản phẩm | Hình ảnh | Mã đặt hàng/sản phẩm | Đơn vị tính | Số lượng | Chọn vào giỏ hàng |
|---|---|---|---|---|---|
| BacterPlate™ Tryptic Soy Agar (TSA) | ![]() | 4102013 | Đĩa |
